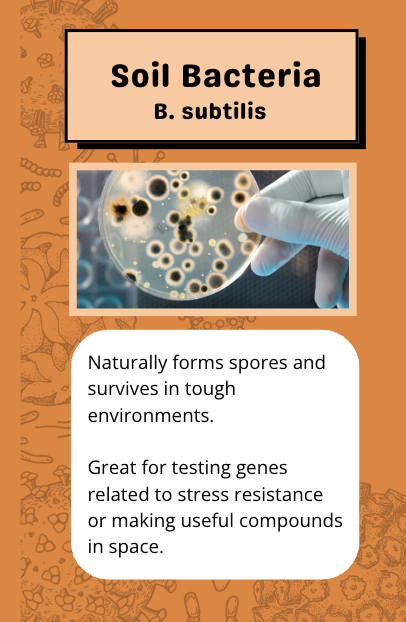
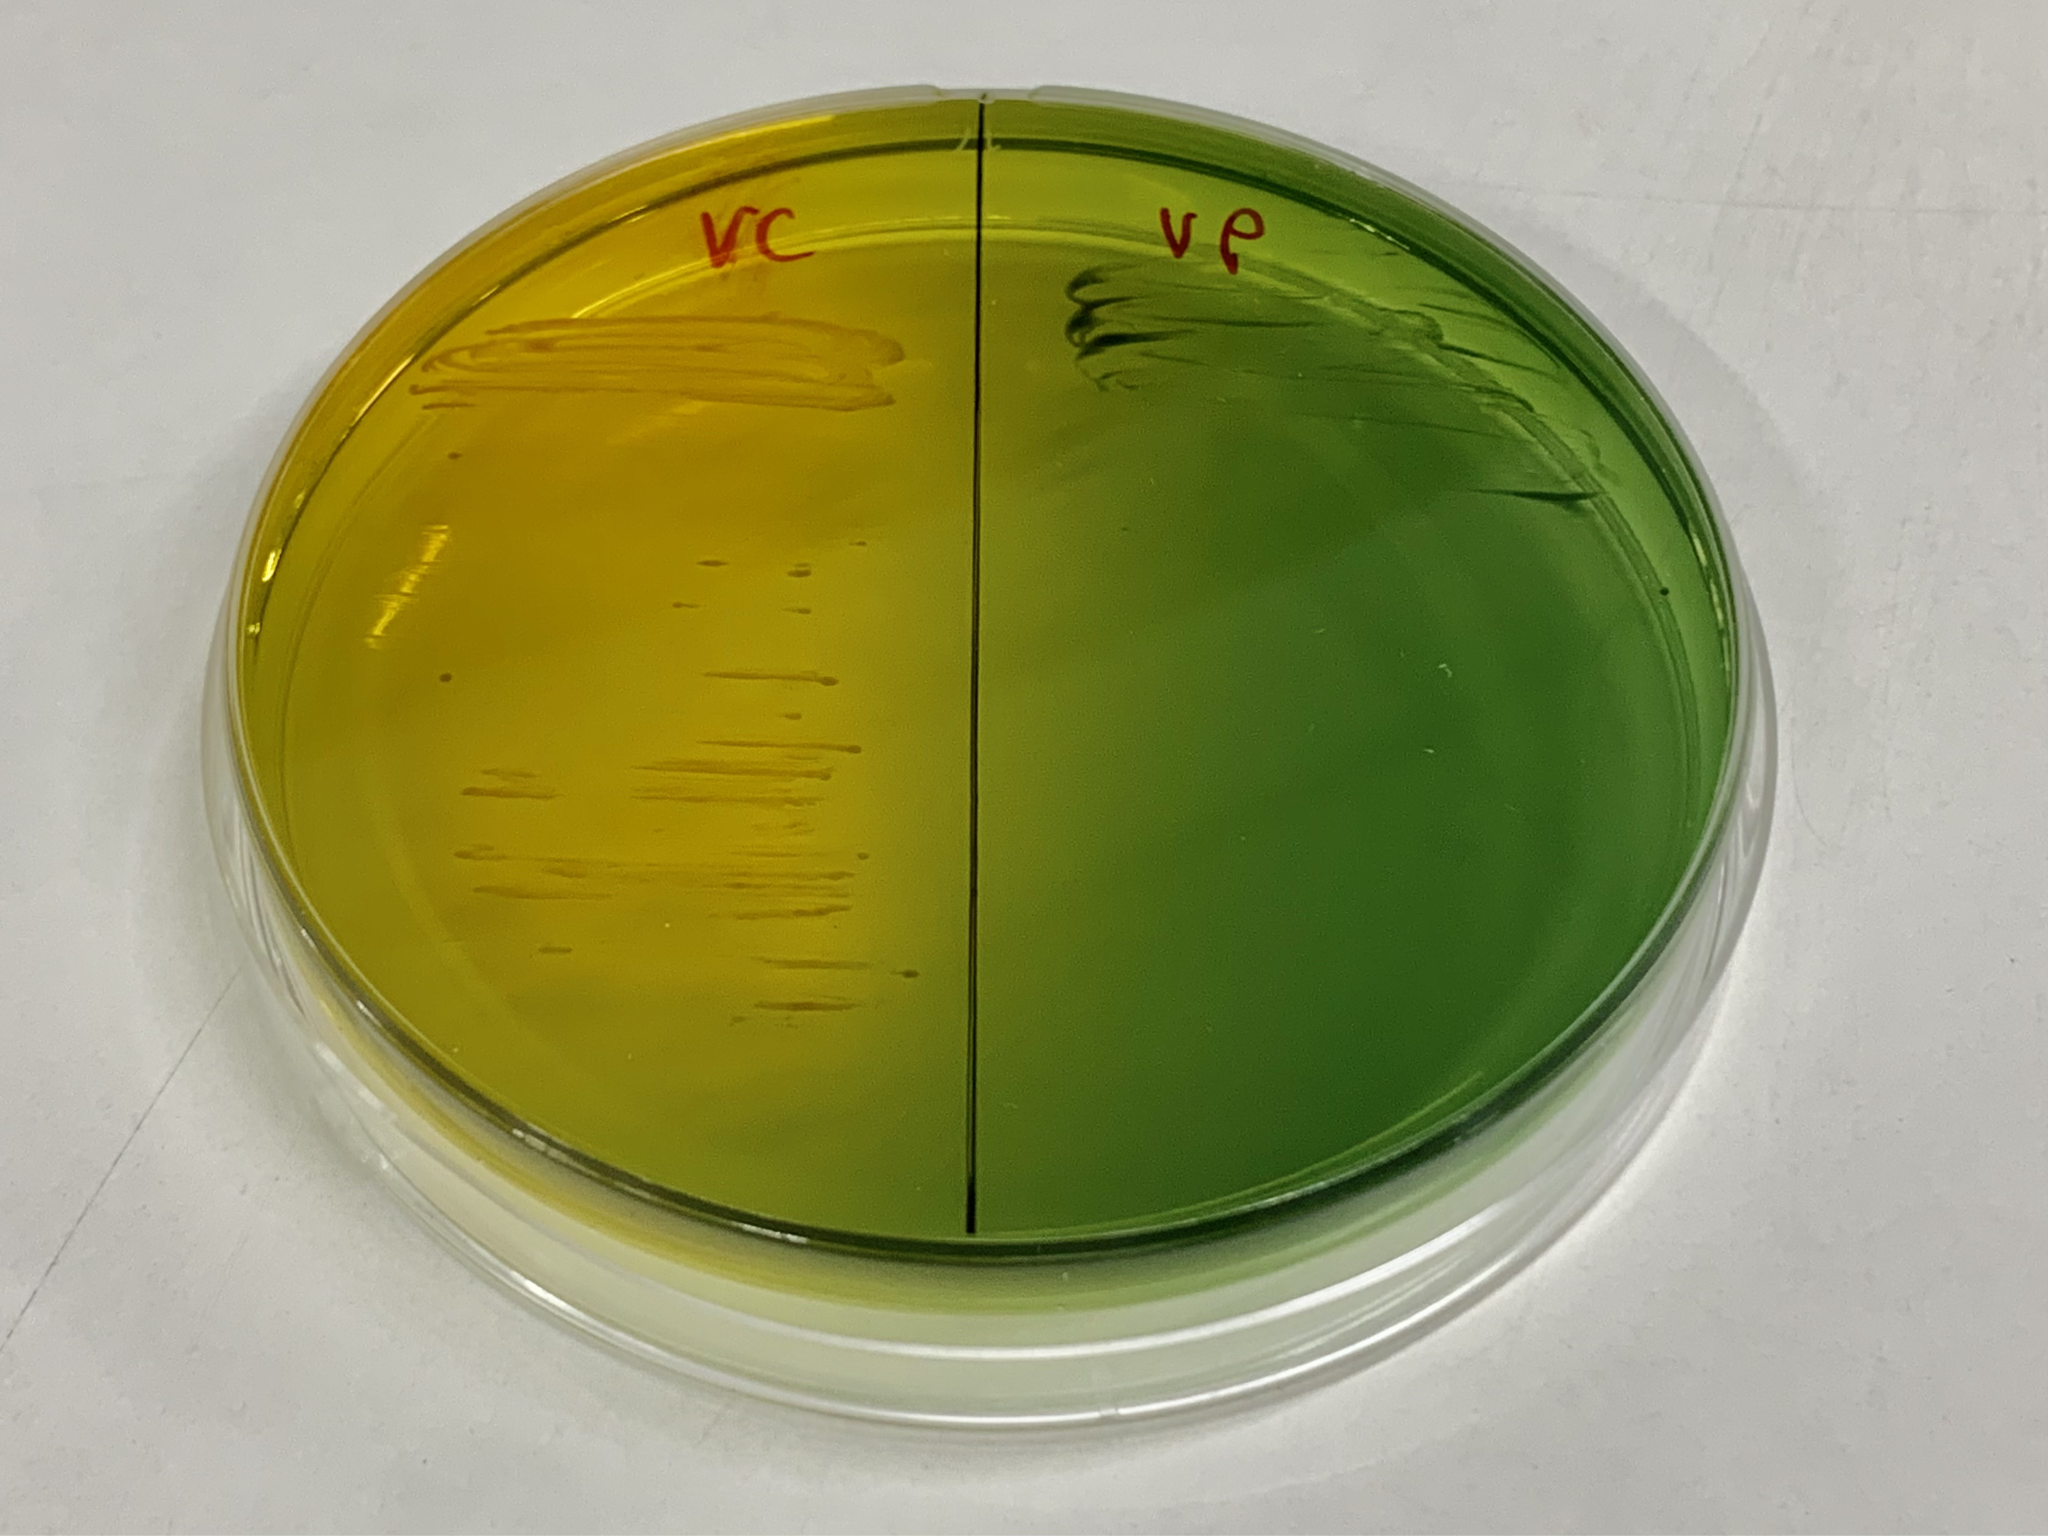

A Plasmid Design Game to Teach Genetic Engineering
In partnership with the MIT Museum, we have developed a gamified educational activity to teach students and museum visitors about the process of genetic engineering!

A continuation of the AstroBio Design Activity…


First: Join a Lab, Solve a Problem
Participants pick a lab card to join, then determine a problem they want to solve and an organism they will engineer to solve it

Next: Pick Genes, Build a Plasmid
Participants learn the design rules of DNA, then work together to assemble a plasmid that will give their organism the properties they desire.
Pick from different promoters, functional genes, terminators, antibiotic selection markers, and origins of replication



Then: Assemble Your Plasmid in Lab
Participants run simulations of a Polymerase Chain Reaction (PCR) and Gel Electrophoresis to “assemble” their plasmid designs in the lab. Then they simulate a Gibson Assembly to see if their plasmid was correctly designed!
Participants must select the correct DNA bands from their virtual gels, then ‘plate bacteria’ on a color-changing plate to see if it was correctly designed.

Finally: Engineer Your Organism!
After correctly assembling their plasmid designs, participants receive a generated image of their engineered organism solving their chosen problem!

Thank you to the hundreds of students and museum visitors who have helped play, test, and improve this game design
Special thank you to Ola Jachtorowicz and Leah Hughes, who made this all possible